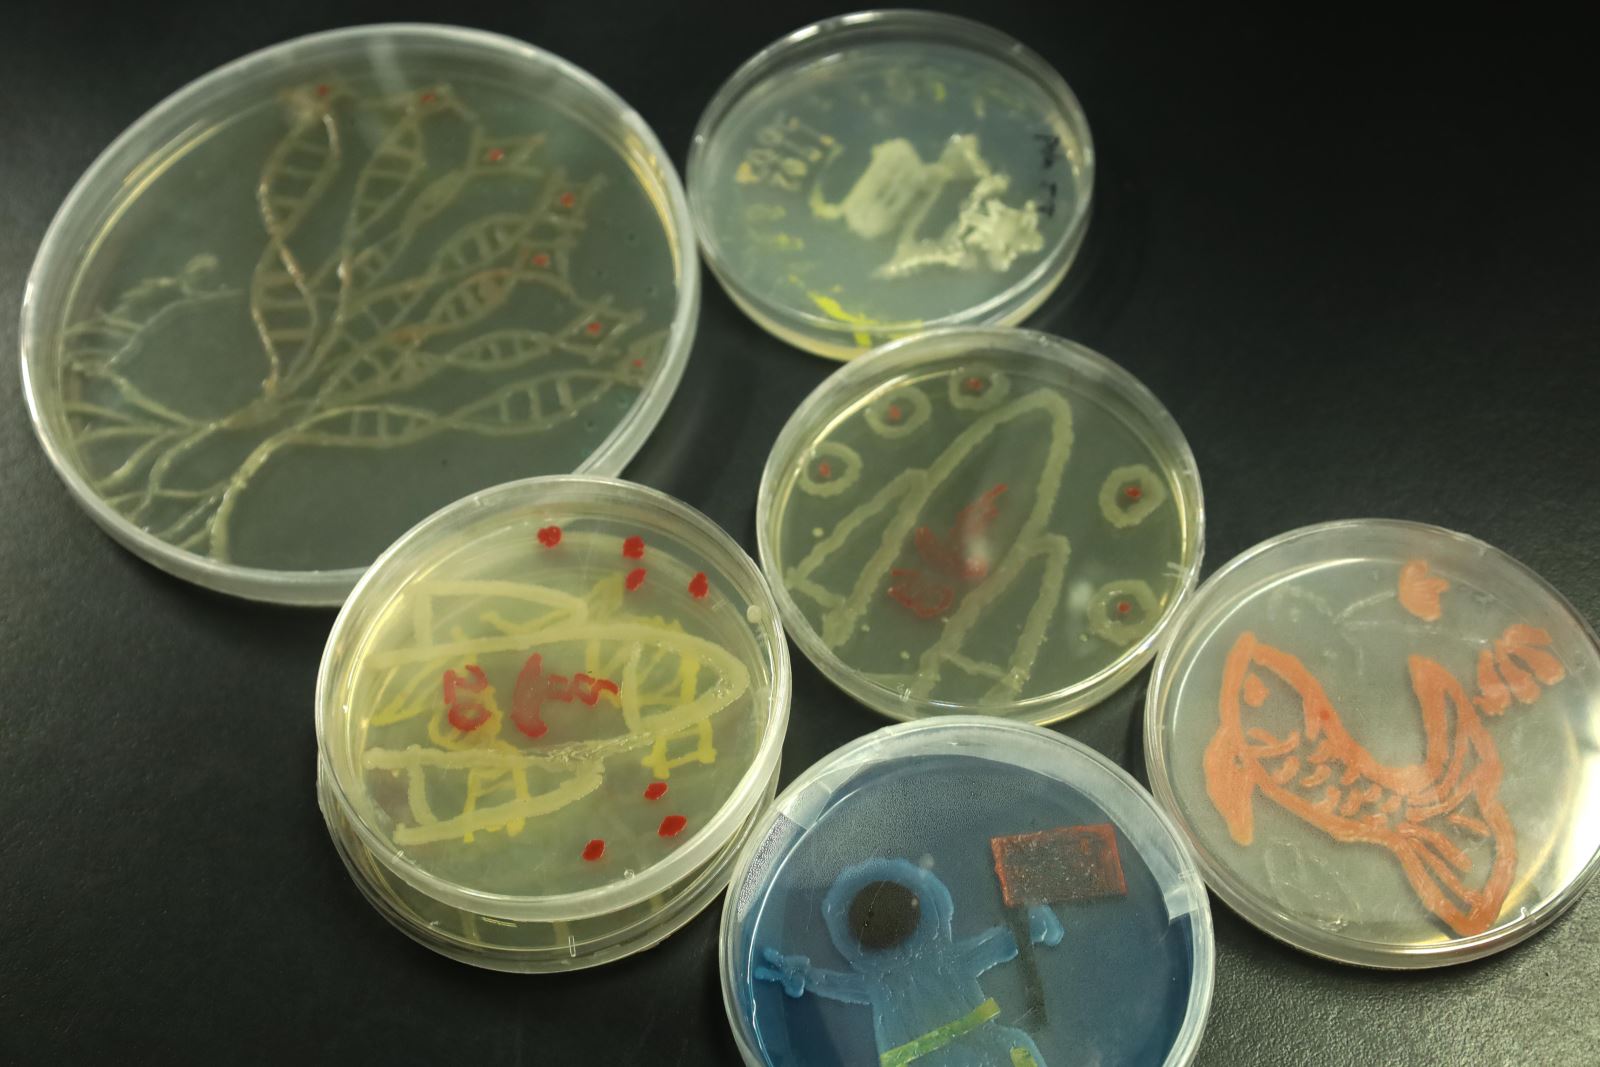

5月20日晚7点,南京农业大学第六届琼脂艺术大赛决赛在生科楼C5029举行,出席决赛的评委有生命科学学院教授闫新、王卉。此前经过初赛选拔的八个小组将自己的作品实物和照片结合,并进行汇报。评委将根据选手们作品的创意、展示、完成程度选出一二三等奖及优秀奖。

在南京农业大学建校120周年和生科院建院20周年之际,弓奕组将120以数字的形式表现在自己的作品中,以微生物绘画创作的方式为母校生日献礼。徐珂组的作品“月下棹神舟,星夜赴天河”展现了对母校发展的美好祝愿。耿溥泽组的作品“手可摘星辰”则是巧妙地融入了北斗七星、DNA双螺旋结构、神经元的形象,除常规微生物培养外,还使用了噬菌斑和荧光微生物进行创作,在紫外线的照射下可呈现出另一番美丽的景象。

在各组展示结束后,王卉教授对各组的作品进行了点评和指导。最终,耿溥泽组获得本次大赛一等奖,徐珂组和王美丁组获得二等奖,张宇轩组、王燕苗组、陈敏组获得三等奖,李若菡组,弓奕组获得优秀奖。